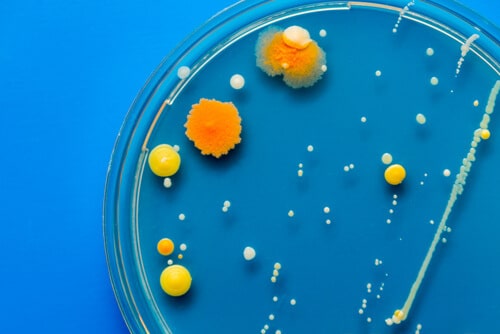
Nueva ISO 7218 Un pilar indispensable en la calidad en los laboratorios microbiológicos

Noticias y Artículos
Últimos posts y noticias
20 años garantizando exactitud y calidad
31/12/2024
¿Cómo calibrar una balanza de laboratorio?
23/12/2024
Unidades de medida de masa y peso
01/10/2024
¿Qué es el control metrológico?
14/06/2024
¿Qué es la metrología industrial?
30/05/2024
Implantación de la Norma ISO 17025
30/01/2024
Patrones de medida
27/07/2023